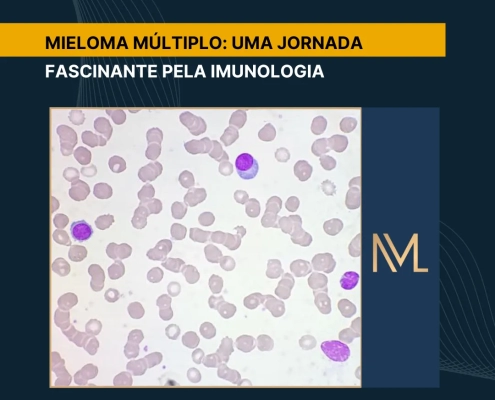

Testes Sorológicos: Aplicações, Vantagens e Limitações
A imunologia clínica desempenha um papel vital na prática médica, sendo fundamental para o diagnóstico, tratamento e acompanhamento de uma variedade de doenças. Dentro deste cenário, os testes sorológicos se destacam como ferramentas…

Saiba Como Erros Pré-Analíticos Comprometem Seus Resultados
Entre todas as etapas do processo laboratorial, a fase que antecede a análise concentra a maioria dos erros pré-analíticos.
Essa fase inicial, que engloba desde a solicitação do exame até o início do processamento da amostra, concentra…

Sistema Hemostático na Gravidez: Riscos Tromboembólicos
O sistema hemostático na gravidez passa por profundas alterações fisiológicas que têm como objetivo preparar o organismo materno para a gestação, porém o parto é um momento crítico e o sistema se modula para minimizar os riscos de…

Aplicações da Tabela de Rümke na Rotina da Hematologia Clínica
A Tabela de Rümke é uma ferramenta estatística indispensável no laboratório de hematologia.
Mais do que um conceito teórico, ela atua como um instrumento prático que assegura precisão e confiabilidade nas contagens diferenciais…
Mieloma Múltiplo: Uma Jornada Fascinante pela Imunologia
O mieloma múltiplo (MM) é uma doença complexa, mas para nós, que trabalhamos no laboratório, ela se torna ainda mais instigante.
Dessa forma, é aqui que a imunologia laboratorial se revela uma verdadeira detetive, buscando pistas…

Troponinas Ultrasensíveis: Detecção e Diagnóstico na SCA
O coração, um órgão vital, demanda avaliação precisa em diversas condições. Nesse sentido, os biomarcadores cardíacos, como as troponinas, surgem como ferramentas cruciais para o diagnóstico e prognóstico de pacientes com Síndrome…

Coagulação Intravascular Disseminada: Diagnóstico e Monitoramento
A Coagulação Intravascular Disseminada (CIVD) é uma condição clínica complexa caracterizada por uma ativação generalizada e desregulada do sistema de coagulação.
Essa condição pode ser desencadeada por vários fatores subjacentes,…

Leucemia Mieloide Crônica (LMC): Aspectos Hematológicos Essenciais
A Leucemia Mieloide Crônica (LMC) é uma neoplasia mieloproliferativa que se origina na medula óssea, caracterizada pela proliferação descontrolada de células mieloides maduras e em maturação.
Nesse sentido, sua marca distintiva…

Anticoncepcionais e Tromboembolismo Venoso: Uma Perspectiva Laboratorial
Os anticoncepcionais orais (ACOs), amplamente utilizados para o controle da natalidade, exigem uma análise clínica aprofundada devido ao seu impacto no risco de tromboembolismo venoso (TEV).
Logo, este risco está intrinsecamente ligado…

Hemostasia Secundária: Modelos de Cascata e da Superfície Celular
A hemostasia secundária é a fase crucial em que o tampão plaquetário inicial é consolidado pela deposição de fibrina, formando um coágulo estável e duradouro.
Tradicionalmente, esse processo é descrito pela cascata da coagulação,…
